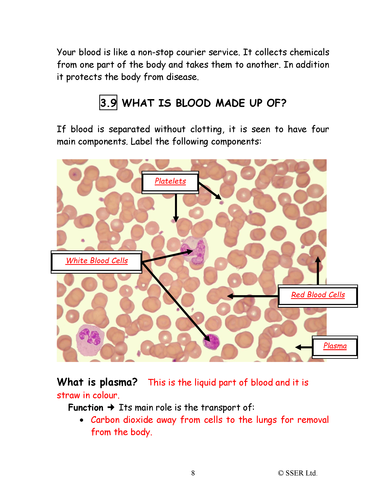
png, 1.7 MB

This workbook pack (3 x 12 pages) supports the presentation of the same name. The workbook is provided in both colour and greyscale versions together with the answers in a teacher’s version.
Currently, the TES store for Premium Resources only allows a standard preview of a MS Word document to consist of three pages. Therefore, we have included a full set of slide images (.png files) to allow you to appreciate the full content of this workbook - you do not need to retain these images after download - just keep the .docx files.
Get this resource as part of a bundle and save up to 3%
A bundle is a package of resources grouped together to teach a particular topic, or a series of lessons, in one place.
Something went wrong, please try again later.
This resource hasn't been reviewed yet
To ensure quality for our reviews, only customers who have purchased this resource can review it
Report this resourceto let us know if it violates our terms and conditions.
Our customer service team will review your report and will be in touch.